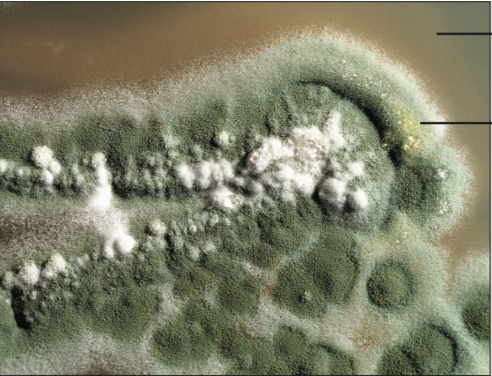
term image

Bio Lab Exam Image Identification
1/38
There's no tags or description
Looks like no tags are added yet.
Name | Mastery | Learn | Test | Matching | Spaced | Call with Kai |
|---|
No analytics yet
Send a link to your students to track their progress
39 Terms

Liverwort
Phylum: Hepaticophyta
Species: Marchantia

Liverwort
Phylum: Hepaticophyta
Species: Marchantia

Gemmae Cups
Liverwort

Gemmae Cups
Liverwort

Moss
Phylum: Bryophyta
Mnium

Rhizopus Sporangium
Bread Mold
Phylum: Zygomycota

Rhizopus
Bread Mold
Phylum: Zygomycota

Sac Fungi
Phylum: Ascomycota

Sac Fungi
Phylum: Ascomycota
(not edible, very deadly)
Penicillium
Phylum: Ascomycota

Peziza Asci
Phylum: Ascomycota

Club Fungi
Phylum: Basidiomycota

Club Fungi
Phylum: Basidiomycota

Club Fungi
Phylum: Basidiomycota

Crustose lichen

Fruticose lichen

Foliose lichen

Ginkgo
Phylum: Ginkgophyta
Gymnosperm

Ginkgo
Phylum: Ginkgophyta
Gymnosperm

Moon Sea Jelly
Phylum: Cnidaria

Sea Anemone
Phylum: Cnidaria
Class: Anthozoa

Box Jelly
Phylum: Cnidaria
Class: Cubozoa

Sponge
Phylum: Porifera

Flatworm
Phylum: Platyhelminthes

Flatworm
Phylum: Platyhelminthes

Tapeworms
Phylum: Platyhelminthes
Class: Cestoda

Snail (Gastropoda)
Phylum: Mollusca

Octopus (Cephalopoda)
Phylum: Mollusca

Fern Sporangia (sori)
Phylum: Pterophyta

Fiddlehead (Fern)
Phylum: Pterophyta

Whisk ferns
Phylum: Pterophyta

Strobili- Club Moss
Phylum: Lycophyta

Club Moss
Phylum: Lycophyta

Quillwort (Isoetes)
Phylum: Lycophyta

Pinworm (Roundworm)
Phylum: Nematoda

Common Polychaete
Phylum: Annelida

Earthworm
Phylum: Annelida

Earthworms
Phylum: Annelida

Leeches
Phylum: Annelida